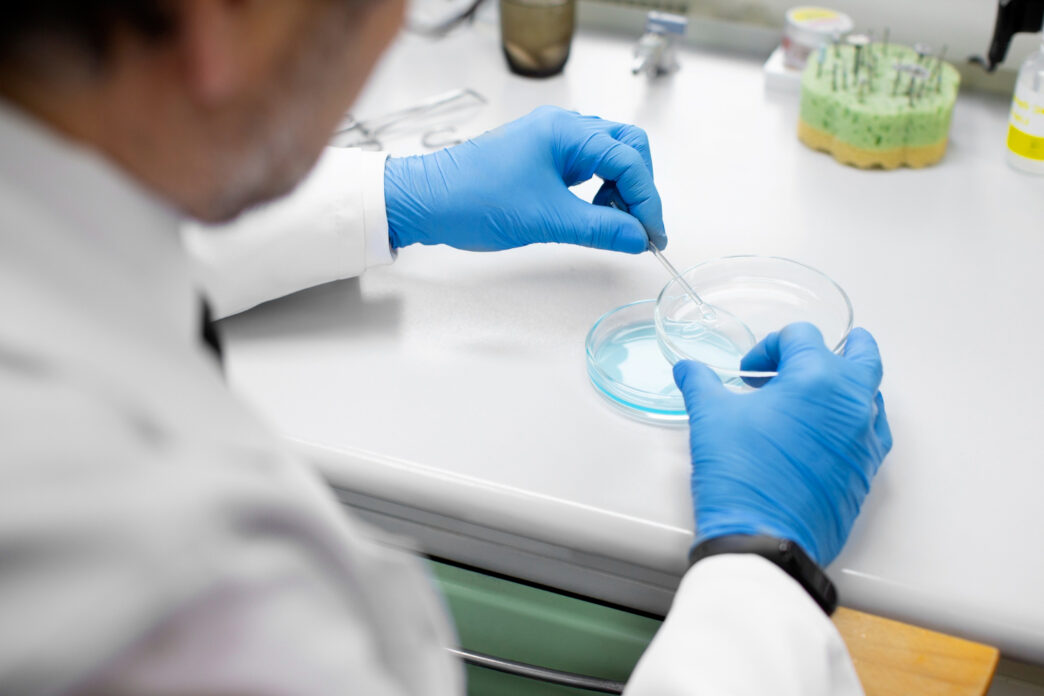

Користувачка нашого сервісу розповіла, що відвідала манікюрний салон, в якому неякісно дезінфікують інструменти, і тепер боїться заразитися золотистим стафілококом. Вона цікавиться, як перевіритися на золотистий стафілокок, щоб у разі виявлення інфекції розпочати лікування якомога швидше. Переживання не безпідставні – ця бактерія справді передається переважно через контактно-побутовий шлях (дотики, предмети побуту, рушники, дверні ручки) та повітряно-крапельно (кашель, чхання), а також з їжею (креми, молочні продукти), через рани та медичні маніпуляції. Збудник часто живе на шкірі здорових людей, але при зниженні імунітету може спричинити серйозні інфекції, тому гігієна рук та дотримання стерильності є критично важливими.
Коли варто перевіритися?
Здати аналізи можна і профілактично, якщо є підозра на інфікування. Але є ряд симптомів, які більш чітко вказують на необхідність перевірки.
Шкіра:
- Почервоніння, набряк, свербіж та біль.
- Гнійні висипання: фурункули (чиряки), карбункули, імпетиго, гідраденіт.
- Нагноєння ран, порізів.
Горло та дихальні шляхи:
- Ангіна, тонзиліт: біль у горлі, висока температура, гнійний наліт, збільшені мигдалики.
- Пневмонія, бронхіт: кашель (сухий чи з мокротинням), задишка, біль у грудях.
- Риніт, синусит: нежить, закладеність носа.
Вуха:
- Біль, набряк, закладеність, гнійні виділення з неприємним запахом, погіршення слуху.
Шлунково-кишковий тракт:
- Через 2-6 годин після їжі: сильні болі в животі, нудота, блювота, діарея, зневоднення.
Очі:
- Кон'юнктивіт: почервоніння, сльозотеча, гнійні виділення, світлобоязнь.
Сечостатева система:
- Цистит, вульвовагініт: печіння, свербіж, дискомфорт, виділення, часте сечовипускання.
Симптоматика залежить від особливостей інфікування. Наприклад, шкірні симптоми характерні в основному для контактного інфікування, а прояви з боку шлунково-кишкового тракту – для харчового отруєння.
Загальні симптоми (при інтоксикації):
- Підвищення температури тіла (лихоманка).
- Загальна слабкість, головний біль.
- Відсутність апетиту, безсоння.
- У важких випадках – сепсис (різке погіршення стану, тахікардія, падіння тиску, поліорганна недостатність).
Які аналізи здати?
- Бактеріологічний посів. Висівання матеріалу на живильне середовище, інкубація та виявлення колоній. Найпоширеніший і найінформативніший метод, який часто включає антибіотикограму.
- Мікроскопія. Виявлення бактерій під мікроскопом після фарбування мазка (за Грамом).
- ПЛР (Полімеразна ланцюгова реакція). Для швидкого виявлення ДНК збудника.
- Серологічні дослідження. Визначення антитіл у крові (ІФА, РНГА), використовується для хронічних інфекцій.
Підготовка до аналізу:
- Припинити прийом антибіотиків за 1-2 тижні до дослідження.
- Мазки з носа/зіву брати натщесерце або через кілька годин після їжі, не чистити зуби, не жувати гумку.
- Припинити використання антисептиків в ділянці взяття матеріалу за 24 години.
Пам’ятайте про важливість профілактики – вона полягає в першу чергу в суворому дотриманні гігієни, особливо миття рук, обробці мікротравм, дезінфекції поверхонь, а також у зміцненні імунітету через здоровий спосіб життя. Якщо ви хочете отримати більше порад щодо захисту від інфекцій, скористайтеся можливістю безкоштовно поставити запитання лікарю онлайн на форумі CentrMed.